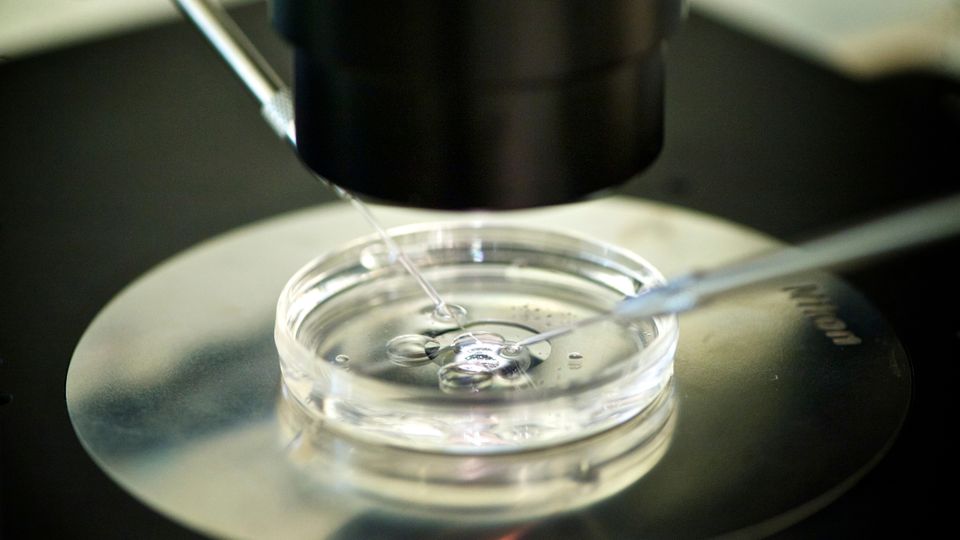

2025-07-07
https://www.spiegel.de/wissenschaft/fortpflanzungsbiologie-kommen-spermien-und-eizellen-bald-aus-dem-labor-a-cd934fbb-dc47-4288-9b34-fb0a3502657b
HaiPressimage">
Bild vergrößern
Zellforschung im Labor: Wissenschaftler spricht von zukünftigen Durchbrüchen
Foto: BSIP / Universal Images Group / Getty Images
Laut einem Bericht der britischen Zeitung »The Guardian« werden Wissenschaftler möglicherweise bald in der Lage sein,lebensfähige menschliche Geschlechtszellen im Labor zu entwickeln. Katsuhiko Hayashi,ein renommierter Entwicklungsgenetiker der Universität Osaka,erklärte der britischen Zeitung
,dass sein Team innerhalb der nächsten sieben Jahre fähig sein könnte,aus Haut- oder Blutzellen Spermien und Eizellen zu erzeugen. Dieses Verfahren,bekannt als »In-vitro-Gametogenese« (IVG),könnte die Fortpflanzungsbiologie revolutionieren und neue Möglichkeiten für Menschen schaffen,Kinder zu bekommen – unabhängig von Alter oder Fruchtbarkeit.
data-area="text" data-pos="15">
In Deutschland und Großbritannien wären laborkultivierte Geschlechtszellen nach geltendem Recht nicht für Fruchtbarkeitsbehandlungen zugelassen. Experten betonen,dass umfangreiche Tests notwendig seien,bevor die Technologie für den klinischen Einsatz in Betracht gezogen werden kann.
bre